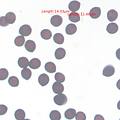
WRJ 0061

Demo Mode - Read Only
You're viewing a specimen from the demo collection. Sign in or create an account to add your own mushroom specimens and use all features.
Showing mushroom:
- Fairhope, Baldwin County, Alabama, United States Fungus Type: Gills
- Parasola plicatilis
- Description
- https://www.inaturalist.org/observations/326511877 Pleated Inkcap
Name: WRJ 0061
Collection Date: 07-07-2023
Identification(s):